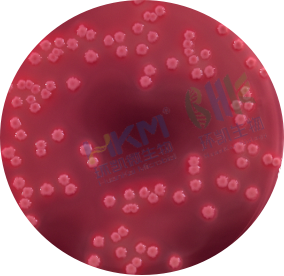
粉红色菌落周围有胆酸沉淀环

2025版中国药典标准菌种确认解决方案 -大肠埃希氏菌
发布时间:2025-09-22 浏览次数:64
随着2025版《中国药典》的颁布和实施,对制药企业微生物检验人员的技术能力提出更高要求,且菌种确认和鉴定也成为了大家极为关注的焦点。
因此,环凯依据《中国药品检验标准操作规范》、2025版《中国药典》四部通则9204 微生物鉴定指导原则和《伯杰氏系统细菌学手册》现行版,给大家提供菌种确认的整体解决方案。

注:“+”代表阳性反应;“-”代表阴性反应。
| 大肠埃希氏菌CMCC(B)44102菌种确认试剂解决方案(参考中国药品检验操作规范) | ||||
| 名称 | 货号 | 规格 | 备注 | 大肠埃希氏菌的特征 |
| 麦康凯琼脂平板 | 022143 | 250g,干粉 | 用于大肠埃希氏菌纯度和菌落特征确认 | 粉红色菌落周围有胆酸沉淀环
|
| 022143P1 | 250g,颗粒 | |||
| CP2143B1 | 90mm×10个 | |||
| 麦康凯琼脂培养基(2025ChP/EP/USP)-广东环凯微生物 /show/20654.html | ||||
| MUG培养基 | 028265 | 250g,干粉 | 用于大肠埃希菌利用MUG产荧光特征确认。 | 产荧光
|
| CP0900 | 5ml×20支,成品管装 | |||
| 4-甲基伞形酮葡糖苷酸(MUG)培养基-广东环凯微生物 /show/20357.html | ||||
| 革兰氏染色液 | 029010 | 10ml×4瓶 | 用于显微形态确认。 | 革兰氏阴性短杆菌
|
| 革兰氏染色液-广东环凯微生物 /show/21027.html | ||||
| EasyID大肠埃希氏菌IMVC生化鉴定试剂盒 | HKI001 | 10test | 检测项目:靛基质、MR、VP、西蒙氏柠檬酸盐 | 靛基质(+)、MR(+)、VP(-)、西蒙氏柠檬酸盐(-)
|
| EasyID大肠埃希氏菌IMVC生化鉴定试剂盒(细菌生理生化鉴定试剂条)-广东环凯微生物 /show/20849.html | ||||
| 结论:标准菌株CMCC44102经上述试验确认符合大肠埃希氏菌的特性 | ||||